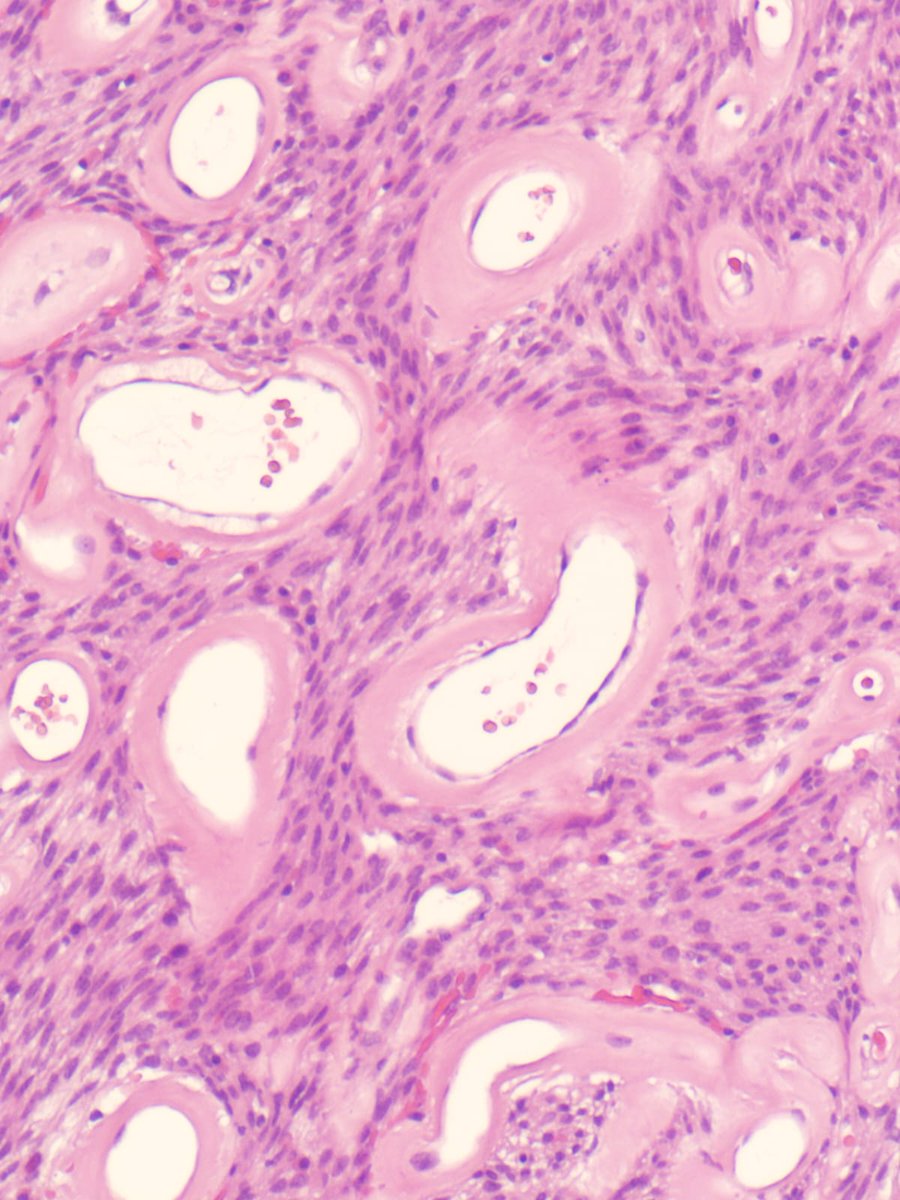
A 70 year old gentleman presented with right sided nasal obstruction and nasal discharge, was found to have a 5 cm right nasal mass. 
Excision of the mass was performed. 
What is your opinion?
#ENTpath
#Headneckpath
#Pathtwitter 
#PathX

Aanchal Kakkar
@aanchalkakkar
Additional Professor at @AIIMS_Pathology
#ENTpath #headneckpath #pedipath
ID: 79559414
03-10-2009 20:35:43
5,5K Tweet
1,1K Followers
655 Following



Thrilled 🥳 to share our in-depth review of Sinonasal undifferentiated and poorly differentiated carcinomas in Surgical Pathology Clinics' special issue on sinonasal pathology edited by Jim Lewis Jr. Catch it at: sciencedirect.com/science/articl… #ENTpath #headneckpath #Pathology

Hello Nasal mass 32 Female Any thoughts please ? Hisham Alshuaibi Olaleke Folaranmi Cleveland Clinic Head and Neck Pathology Dan Graham PATH





The much awaited International Consensus Recommendations on diagnostic criteria & terminology for extranodal extension (ENE) in HNSCC, an HN CLEAR initiative, is now out in Head Neck Pathol Freely accessible for now!👇 #ENTpath #HNpath link.springer.com/epdf/10.1007/s…





🏆 In the past month, we have added 2 feathers to our cap: 🌍Ranked 22nd Best Medical School in the World 🇮🇳 Ranked Best Medical College in India IndiaToday Proud to keep raising the bar for medical education and healthcare! bestcolleges.indiatoday.in/news-detail/me… ceoworld.biz/2025/04/06/bes…



New article alert! 🚨 We published our observations on the utility of BSND IHC in Oncocytic 🌸 salivary gland tumors in Human Pathology Elsevier Pathology Would you want to use BSND in your lab?! 🤩 kwnsfk27.r.eu-west-1.awstrack.me/L0/https:%2F%2… #ENTpath #headneckpath

Tumour-infiltrating lymphocyte subsets and their individual prognostic impact in oral squamous cell carcinoma"Aanchal Kakkar Munita Bal bit.ly/4kHRnq5


Tumour-infiltrating lymphocyte subsets and their individual prognostic impact in oral squamous cell carcinoma"Aanchal Kakkar Munita Bal bit.ly/4kHRnq5

Tumour-infiltrating lymphocyte subsets and their individual prognostic impact in oral squamous cell carcinoma"Aanchal Kakkar Munita Bal bit.ly/4kHRnq5